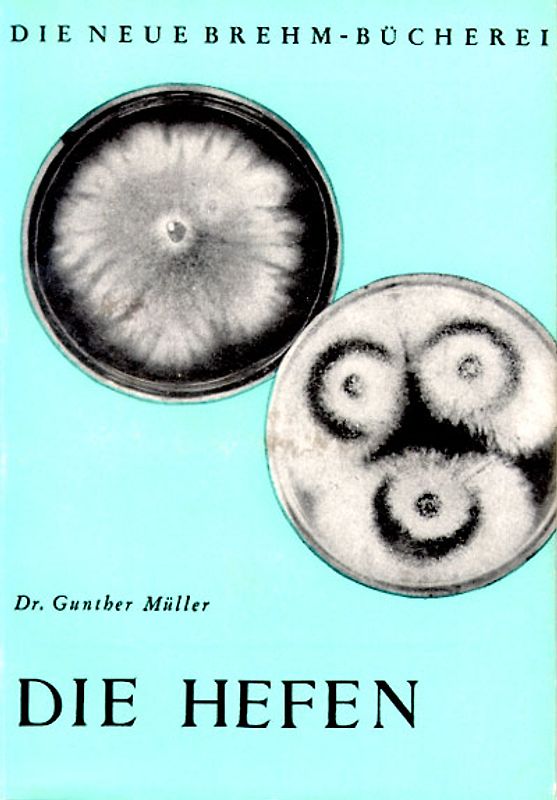
Die Hefen

Handgeprüfte Gebrauchtware
Bis zu 50 % günstiger als neu
Der Umwelt zuliebe
Handgeprüfte Gebrauchtware
Bis zu 50 % günstiger als neu
Der Umwelt zuliebe
Hersteller: Militzke Verlag GmbH, Gerichtsweg 28, Leipzig, Deutschland, 04103, info@militzke.de, Michael Wolf